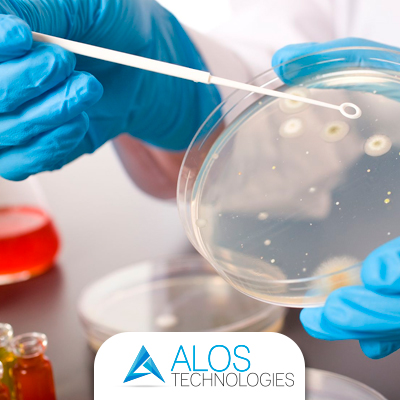
Rischio microbiologico dell'aria

Alos Technologies - ultime notizie
La sezione riporta le novità nei servizi e nelle attività di progettazione, di produzione e di commercializzazione dei dispositivi medici; di apparecchiature per i monitoraggi dei Gas e dell'ambiente. Un canale sempre puntato sulle più recenti scoperte dei sistemi nel settore della sanità, per una migliore informazione e conoscenza di tutti.

- Dettagli
- Scritto da Creare
All'interno di ogni sala operatoria, ambulanza o reparto di terapia intensiva si trovano dei monitor multiparametrici. Questi monitor negli ospedali e nelle cliniche servono per tenere sotto controllo i parametri vitali del paziente, sono una vera e propria lettura dello stato di salute delle persone.

- Dettagli
- Scritto da Creare
Negli ospedali e in particolare all'interno delle sale operatorie viene spesso richiesta l'attivazione della ventilazione artificiale, o anche conosciuta come ventilazione meccanica.
Questo tipo di ventilazione ha lo scopo di aiutare coloro che non hanno un'attività polmonare normale e che quindi non riescono a portare a termina la respirazione autonomamente, oppure per far inalare gas anestetici o rianimare un paziente.

- Dettagli
- Scritto da Creare
All'interno degli ospedali esistono zone dove la pulizia, l'efficienza e il corretto funzionamento degli strumenti assumono una rilevanza vitale. Tra queste indubbiamente una delle più importanti è la sala operatoria.
All'interno si trovano strumenti e dispositivi medici di tutti i tipi ma adesso concentreremo l'attenzione sulla lampada scialitica.

- Dettagli
- Scritto da Creare
All'interno degli ospedali gli standard e la qualità degli impianti devono rispondere a delle caratteristiche ben precise perché ogni malfunzionamento potrebbe portare a conseguenze gravissime. Tra le attività più critiche rientra indubbiamente quella dell'erogazione dei gas medicali, frutto di un'attenta pianificazione e gestione degli impianti gas ospedalieri.
Alos Technologies dispone di un team altamente specializzato che non si ferma alla progettazione degli impianti gas ospedalieri ma che segue il progetto lungo tutta la sua realizzazione.

- Dettagli
- Scritto da Creare
Negli ultimi anni l'attenzione si è condensata su un tema molto importante, quello dei batteri. Si sente parlare di escherichia coli, di batteri sopravvissuti a mezzo milione di anni oppure del batterio resistente agli antibiotici.
Il punto è che è assolutamente normale sentir parlare dei batteri dato che costituiscono senza dubbio gli organismi più numerosi del pianeta. Se pensiamo che il nostro corpo ospita più di dieci mila specie di batteri differenti e che nel nostro intestino ce ne sono più di un miliardo non è difficile intuire il motivo per cui molte persone diventino ipocondriache nel momento in cui lo vengono a scoprire.
- Dettagli
- Scritto da Creare
Nell'ultimo ventennio l'interesse per il rischio microbiologico dell'aria ha assunto un peso rilevante sia per la salute della persona che per le attività commerciali. I microrganismi diffusi nell'aria infatti, non rappresentavano ancora una minaccia potenziale alla salute delle persone e l'attenzione si focalizzava principalmente sugli inquinanti chimici.
Il rischio microbiologico dell'aria invece deriva anche da tutti quei microrganismi come batteri, funghi e virus che, in grado di resistere agli agenti esterni, minacciano la salute di tutti gli individui con i quali hanno possibilità di entrare in contatto. Per questo motivo diventa essenziale un'analisi microbiologica dell'aria seguita da attività di disinfezione dell'aria capace di rispondere ai più alti standard di qualità sul mercato.
